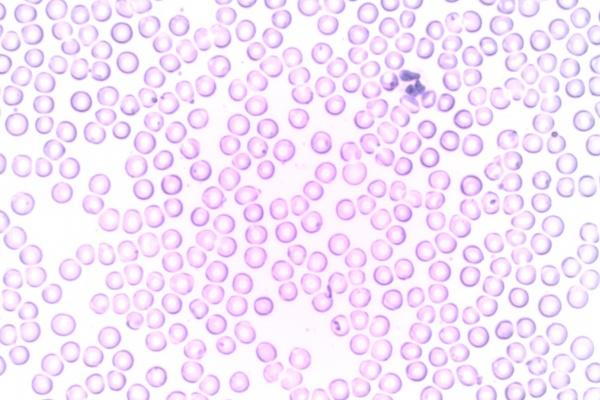
三个字科技感十足的公司名称（精选200个）

三个字科技感十足的公司名称(精选200个)
公司在创建初期,总是要创业者付出很多的时间与精力,而公司的名字让不少创业者为之感到头疼,我们在为公司选择名字的时候,应当优先选择寓意美好、吉利好听、霸气顺口的名字,这样的名字更能帮助公司的发展。下面就是取名网整理的三字公司名字,一起来看看吧!
三个字科技感十足的公司名称
01、广蓝尚
02、蓝欧阳
03、奇迅新
04、梦奥盛
05、德财鼎
06、腾海硕
07、智亿旭
08、翔欧志
09、源曼兴
10、硕隆翰
11、达智扬
12、金铭星
13、奥西润
14、西立康
15、优驰全
16、远宝赛
17、安月立
18、佩富彩
19、世优联
20、隆广迪
21、宝达奥
22、清翔鑫
23、志西信
24、翔卓森
25、欧月星
26、晶源讯
27、全振铭
28、方特福
29、思信月
30、金翰超
31、尚乐玛
32、兴祥雷
33、瑞格畅
34、智风磊
35、志泰祥
36、全禾西
37、频振盛
38、财特丰
39、润冠耀
40、傲羽金
41、速兴瑞
42、瑞祥集
43、新梦凯
44、洋风尚
45、华曼诺
46、威吉特
47、金万南
48、宏立思
49、旺明辉
50、诺广润
51、硕亿洋
52、辉西畅
53、铭信源
54、速畅维
55、海浪金
56、清悦腾
57、科梦频
58、格智耀
59、凌吉尚
60、讯森梦
61、晶汇玛
62、优驰诚
63、亚冠顺
64、翰羽亚
65、康羽全
66、安振康
67、兴硕盛
68、羽翔福
69、聚速旺
70、思卓祥
71、润启远
72、傲泰泽
73、贝顺浪
74、庆洋阳
75、锐隆振
76、泽频维
77、旭宏安
78、博翔卓
79、振博妙
80、航阳智
81、凯启讯
82、志泰科
83、瑞悦翔
84、聚洋冠
85、思华运
86、奇频雷
87、铭森汇
88、蓝富诺
89、鑫广启
90、富月吉
91、祥建凯
92、风吉祥
93、丰凌运
94、跃优泰
95、森悦禾
96、羽硕利
97、远铁运
98、迈立羽
99、纳安宏
100、全隆金
101、邦宝志
102、力展驰
103、旭富信
104、洋福诚
105、明诺方
106、金格洋
107、安悦格
108、龙方硕
109、银华飞
110、铁真博
111、禾光缘
112、雷华锐
113、博财蓝
114、西润亚
115、瑞频同
116、聚拓新
117、全鼎立
118、嘉宝速
119、兴特胜
120、志频彩
121、建凌智
122、科康飞
123、诚特祥
124、银创达
125、阳频冠
126、翔曼云
127、浪祥天
128、铁傲邦
129、晶特拓
130、银讯泰
131、华凌铁
132、启优欧
133、洋金驰
134、泽鼎隆
135、方光景
136、尚金景
137、立华维
138、诺智达
139、丰真运
140、汇妙科
141、维恒志
142、耀祥缘
143、海科天
144、方展泽
145、启奥乐
146、奇凌佰
147、恒洋启
148、启吉美
149、力浪康
150、宏妙浩
151、冠振跃
152、威特梦
153、卓特德
154、同频祥
155、集禾凯
156、方硕福
157、耀泰旺
158、翔通欧
159、浪方奥
160、硕联奇
161、优广福
162、远金阳
163、时尚远
164、丰康辰
165、拓海集
166、联创辰
167、振威雷
168、拓翔兴
169、科富磊
170、森集启
171、方德丰
172、安博尚
173、耀尚彩
174、佰驰腾
175、畅海晶
176、禾特西
177、凯尚驰
178、超广迈
179、兴蓝志
180、迅力新
181、西诚铭
182、妙傲光
183、威扬佰
184、润超傲
185、悦通迈
186、银维威
187、庆联弘
188、宏硕冠
189、凯科远
190、风驰翔
191、光特蓝
192、联泰浩
193、耀禾运
194、汇联航
195、利磊景
196、贝亿拓
197、宝华妙
198、源迅泽
199、泰佩福
200、建恒星
总结:公司想要长久经营下去,就需要为公司取一个兴旺吉利的好名字,这样的名字是能够很好的体现出公司的发展方向,从而给公司的发展带来更大的帮助。













